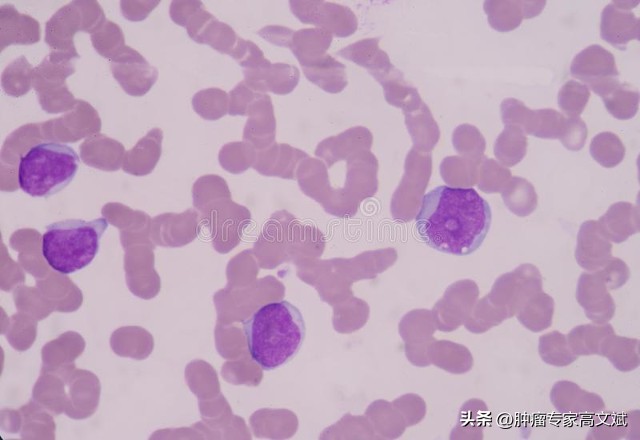
肿瘤患者白细胞升得过高可好,癌症患者白细胞40000高好吗

#挑战30天在头条写日记# @肿瘤科潘文俊#癌症##深圳头条##肿瘤##免疫##白细胞升高##肿瘤防治科普#
说起“白细胞”,这可是一个足够让肿瘤患者、家属和肿瘤科医生都操碎了心的指标。先不说血常规是肿瘤患者日常检查中最为频繁的检验项目,在血常规诸多检查内容中,白细胞的数量和分类也算是我们最为关心的内容了。以至于有很多肿瘤患者说,看着白细胞的数量真有看股票涨跌的感受。
正常情况下,外周血液中白细胞总数一般为3.5×109/L~10×109/L,当外周血中白细胞总数超过10×109/L的时侯,则称为白细胞增多症。对于增多的白细胞成分,主要包括中性粒细胞、嗜酸性粒细胞、嗜碱性粒细胞、淋巴细胞及单核细胞等。临床上也是以中性粒细胞及嗜酸性粒细胞增多最常见,也是对于疾病诊断和患者状态进行判断的重要指标。
中性粒细胞增多症
成年人外周血液中性粒细胞绝对值超过7.5×109/L称为中性粒细胞增多症。肿瘤性中性粒细胞增多首先需要考虑白血病,其次是感染、出血、药物性作用、变态过敏反应、代谢和内分泌紊乱等因素所导致。中性粒细胞增多也可能与肿瘤产生并释放集落刺激因子(CSF)、粒细胞从血循环中清除速度放慢、骨髓与血循环间屏蔽破坏促使骨髓粒细胞进入循环池、外周粒细胞贮存池释放等因素相关。非肿瘤性的中性粒细胞增多则主要见于原发或继发的柯兴综合征、甲状腺功能亢进、风湿病、高渗性脱水、溶血性疾病等。
嗜酸性粒细胞增多症
嗜酸性粒细胞在临床上常与多种疾病相关,特别是寄生虫感染、过敏性疾病、结缔组织病和肿瘤的非特异性反应等。嗜酸性细胞增多的发生具有免疫反应的特征。外周血中嗜酸性粒细胞绝对比例超过4%,或者是绝对值超过0.35×109/L,称为嗜酸性粒细胞增多症。在肿瘤性相关疾病中,多见于白血病、类癌、霍奇金淋巴瘤等疾病。
淋巴细胞增多症
淋巴细胞的数量和比例与年龄具有着直接的关系,婴儿及幼童淋巴细胞绝对值达到或超过9.0×109/L,儿童达到或超过7.2×109/L,成人达到或超过4.0×109/L时称为淋巴细胞增多症。相对性淋巴细胞增多是指淋巴细胞绝对值不超过上述范围,而白细胞分类中淋巴细胞百分数显著增高(>40%)。各种感染、血液和淋巴系统恶性肿瘤都可引起淋巴细胞不同程度增加。
嗜碱性粒细胞增多症
嗜碱性粒细胞主要与感染、过敏或者炎症反应等反应直接相关。血液中嗜碱性粒细胞绝对数高于0.05×109/L称为嗜碱性粒细胞增多症,临床较为少见。主要见于血液相关性疾病、白血病、霍奇金淋巴瘤等。
白细胞增多症的临床诊断一般都是通过血液的化验检查来确定的。包括进行外周血白细胞的计数和分类,对某些患者来说还需要进行全血的细胞、寄生虫、变态反应性疾病及皮肤病、内分泌学、微生物学等有关的实验室检查以及骨髓活检。如出现了类白血病反应,还需要与慢性粒细胞性白血病,或其他的骨髓增殖症等疾病进行鉴别,必要的骨髓穿刺检查和基因检测也是常规项目。
在临床上,单纯的白细胞增多一般无明显的临床症状,因此也无需实施特别的处理措施。但是,对于重要疾病原因的查找和诊断,也是目前实施最为有效的治疗手段和前提。